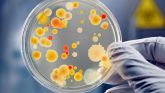
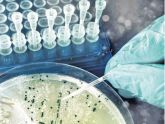

Рубрика "Технологические среды"
1/2022 (87) январь-февраль
- Требования к температуре и влажности воздуха на фармацевтических предприятиях

Установление предельных значений температуры и влажности воздуха в помещении часто дискутируется при проектировании и эксплуатации фармацевтических и биотехнологических предприятий. Какими должны быть пределы значений для сигналов тревоги, и какова приемлемая продолжительность аварийного состояния?
4/2021 (84) июль-август
- Учёт микробиологических факторов при выборе асептических соединителей

Согласно проекту Приложения 1 к GMP ЕС, уполномоченные органы приветствуют применение стерильных технологий и одноразовых изделий. Такая технология может повысить уровень обеспечения стерильности и снизить уровень негативного воздействия фармацевтического предприятия на окружающую среду. Асептические соединители и разъединители – важный пример подобной технологии, которая позволяет продлить линию тока жидкости с помощью устройств, препятствующих проникновению микробного загрязнения...
- Использование поточных анализаторов бионагрузки воды в условиях GMP

Поточные онлайн-анализаторы микробиологической нагрузки воды (Online Water Bioburden Analyzer - OWBA) – это аналитические приборы для измерения бионагрузки в режиме реального или близкого к реальному времени в системах получения, хранения и распределения воды очищенной.
3/2021 (83) май-июнь
- Как подобраться практически к валидации процессов сухожаровой стерилизации и депирогенизации

В различных нормативных документах и руководствах рекомендательного плана основное внимание уделено методу стерилизации. Из двух основных методов термической стерилизации (влажным жаром и сухим жаром) в действующей редакции Приложения больше внимания уделено именно стерилизации влажным жаром. И только один пункт формулирует требования к сухожаровой стерилизации...
- Мониторинг микробов в сжатых газах: стратегии контроля загрязнений на фармацевтических предприятиях

Сжатые газы, такие как азот, углекислый газ и кислород, имеют широкое применение на фармацевтических предприятиях. Процессы, в которых используются сжатые газы, – асептическая упаковка, очистка, фильтрация – являются критическими, эффективность которых должна контролироваться.
2/2021 (82) март-апрель
- Важность контроля ростовых свойств питательных сред
«Учитывая критический характер микробиологических анализов, которые используются для обеспечения безопасности фармацевтических продуктов для медицинского применения, важно проводить контроль качества, гарантирующий, что используемые культуральные среды пригодны для этих целей и работают должным образом» - объясняет Стивен Бримбл из компании Cherwell Laboratories.
1/2021 (81) январь-февраль
- Новые технологии для чистой воды

Фармацевтическая промышленность может преодолеть проблемы качества, используя синергетические методы для оптимизации управления водными ресурсами.
Чистая вода используется на всех этапах фармацевтического производства. Она служит растворителем, наполнителем и реагентом при производстве безопасных лекарств, а также является важным компонентом...
4/2020 (78) июль-август
- Стерилизующий дыхательный фильтр ёмкостей хранения воды для инъекций

В настоящее время вопрос необходимости испытания на целостность дыхательных фильтров на емкостях хранения или приготовления зачастую становится камнем преткновения, поскольку, с одной стороны, они подлежат тестированию на целостность, с другой стороны, нет прямого требования к продуктам, чтобы они были стерильными в каждом из случаев.
- Вода для инъекций: нормативные требования и проект процесса

Путь к пересмотру европейской монографии по качеству воды для фармацевтического применения был очень долгим. Сантьяго Фернандез, главный менеджер компании BWT Iberica, объясняет сам процесс и нормативно-правовую базу.
2-3/2020 (76-77) март-июнь
- Выбор способа санации систем хранения и распределения воды для инъекций: обработка чистым паром или перегретой водой

При проектировании системы хранения и распределения воды для инъекций (ВДИ) инжиниринговой компании или конечному пользователю приходится выбирать способ стерилизации/санитарной обработки (sterilisation/sanitisation) – с помощью чистого пара или перегретой воды. Для принятия решения необходимо более детально рассмотреть каждый из методов, определить их преимущества, недостатки и условия использования для решения поставленных задач.
- Качество сжатого воздуха. Методы анализа частиц и обновления стандарта ISO 8573

Фармацевтические компании используют сжатый воздух во многих направлениях. В виду рисков, связанных с загрязненным сжатым воздухом, производители работают над тем, чтобы обеспечить его надлежащее качество. Допустимые уровни качества сжатого воздуха могут быть определены согласно стандарту ISO 8573 для сжатого воздуха.
1/2020 (75) январь-февраль
- Профилактика загрязнения при перемещении стерильных сыпучих материалов

По мнению Кристиана Дунна, директора направления по стерильной продукции в компании ChargePoint Technology, если не принимать надлежащие меры, стерильные производственные среды могут подвергаться риску со стороны различных потенциальных источников загрязнения.
- Мониторинг производственной среды и испытания на стерильность

Совершенствование производственных процессов и непрерывный мониторинг производственной среды - практические шаги по преодолению проблем при испытаниях на стерильность. Энди Уиттард из компании Cherwell Laboratories обсуждает эти шаги, снижающие риски неудач при проведении испытаний.
6/2019 (74) ноябрь-декабрь
- Проблемы квалификации техники асептической обработки

CQV (Compliance in Quality and Validation) описывает реальные случаи несоблюдения надлежащих практик в фармацевтической промышленности, производстве медицинских изделий и связанных отраслях.
5/2019 (73) сентябрь-октябрь
- Нержавеющая сталь для технологических трубопроводов чистых сред

Для фармацевтических предприятий, выпускающих лекарственные препараты и изделия медицинского назначения, основным материалом «выбора» при проектировании систем распределения чистых сред: воды очищенной, воды для инъекций, чистого пара, продуктопроводов, чистых газов, является нержавеющая сталь марки AISI 316L. Полимерные материалы (полипропилен (PP), поливинилиденфторид (PVDF)), как альтернативные решения, нашли свое применение в большей степени для систем хранения и распределения воды очищенной (хранение при комнатной температуре), а также в микроэлектронике и химической промышленности.
4/2019 (72) июль-август
- Экспресс-методы микробиологических исследований и управляемая производственная среда

Экспресс-методы микробиологических исследований (ЭММИ) (RMM — Rapid Microbiological Methods) продолжают получать признание, и ряд компаний уже добились значительных успехов в определении чувствительности, автоматизации, пропускной способности, времени получения результата и окупаемости инвестиций, когда заменили классические методы инновационными альтернативными технологиями.
2/2018 (66) апрель-июнь
- ПРОЧНОСТЬ И УСТОЙЧИВОСТЬ ТЕХНОЛОГИИ. Заметки о модульной конструкции валидации стерилизующей фильтрации. Часть 2

В предыдущем номере была опубликована структура валидационного пакета финальной стерилизующей фильтрации проекту некоего летательного аппарата для выполнения ответственных миссий. Так он организован, и таковы его модули-компоненты. Основные связи между ними были предметом первой части этой публикации...
2/2017 (62) апрель-июнь
- Перспективы использования технологии ультрафильтрации на этапе предподготовки в системах получения воды очищенной и воды для инъекций

Ультрафильтрация является стандартной технологией водоподготовки. Она зарекомендовала себя как надежный метод получения питьевой и технологической воды из поверхностных источников
- Квалификация системы подготовки, хранения и распределения воды очищенной и воды для инъекций

Вода обладает уникальными химическими свойствами, обусловленными полярностью её молекул и наличием водородных связей. Поэтому она способна растворять, абсорбировать или суспензировать множество различных соединений.
- Микробиологический мониторинг воды для фармацевтических целей в реальном масштабе времени

Редакция журнала «Чистые помещения и технологические среды» уже публиковала статьи, посвященные измерениям взвешенных в воздухе микроорганизмов (биоаэрозолей) в реальном масштабе времени (ЧПТС,2015, №1, с.44; №2, с. 46; №4, с. 70), в которых описан принцип действия счетчиков жизнеспособных частиц...
1/2017 (61) январь-март
- Сравнительная оценка использования ультрафильтрации и многослойного фильтра на стадии предподготовки в системах сверхчистой воды
В настоящей статье сравниваются два метода очистки воды перед подачей ее в установки обратного осмоса: ультрафильтрация и механическая фильтрация, а также рассматриваются некоторые аспекты опыта эксплуатации ультрафильтрации
3/2016 (59) июль-сентябрь
- Обнаруживаем проблемы, находим решения
Почему датчики параметров среды и мониторинг влажности так важны для чистых помещений
3/2016 (59) июль-сентябрь
- Приборное оснащение подразделений контроля чистых производственных помещений

Внимательные читатели журнала знают, что статья с таким названием уже публиковалась в № 3 за 2007 год. Однако за прошедшие с тех пор неполные десять лет практически все упомянутые в ней приборы прошли модернизацию...
- Стандарт ISO 14644-13. Чистые помещения и связанные с ними контролируемые среды. Часть 13: Очистка поверхностей для достижения определённых уровней чистоты в рамках классификации по частицам и химическим загрязнениям

Продолжение. Начало в предыдущем номере
- Что содержит новый стандарт чистоты ISO 14644-13

Новый стандарт ISO 14644. Часть 13, являющийся составной частью Стандарта ISO 14644, опубликован для общественного обсуждения. Тим Сэндл, ВРL, анализирует область и условия применения стандарта ISO 14644.Часть 13
1/2016 (57) январь-март
- Контроль биологического загрязнения фармацевтического производства и соответствия стандарту ISO 14698 при помощи валидированных активных пробоотборников воздуха

Статья опубликована в журнале «Cleanroom Technology», сентябрь 2015 (www.cleanroomtechnology.com)
- Вода, на каждом шагу вода

Статья опубликована в журнале "Controlled Environments", ноябрь-декабрь 2015 (www.cemag.us)
Надежный источник чистой воды является главным условием достижения оптимального качества воды в лаборатории
4/2015 (56) октябрь-декабрь
- Валидация мембранных фильтроэлементов патронного типа и процессов фильтрации

Валидация фильтра имеет решающее значение для обеспечения безопасности пациентов и защиты различных стадий технологического процесса. Тем не менее,...
- Изучение микрофлоры води, используемой для фармацевтических целей, - анализ метаданных

Микробиологические характеристики воды, используемой для фармацевтических целей, изучались в течение пятнадцати лет. Анализу подвергались исходная вода из водопровода, вода очищенная и вода для инъекций (ВДИ).
1/2015 (53) январь-март
- Экономические составляющие систем кондиционирования и вентиляции воздуха в фармацевтическом производстве

Материал к публикации подготовлен специалистами компании ООО «УНИКА Инжиниринг»
- Микробиологический анализ воды в реальном времени
Статья опубликована на сайте журнала «Controlled Environments», (www.cemag.us)
4/2014 (52) октябрь-декабрь
- Орбитальная сварка трубопроводов в системе транспортировки чистых технологических сред

Материал к публикации подготовлен специалистами компании ООО «УНИКА Инжиниринг»
- Увеличение скорости обнаружения патогенных микроорганизмов
Развитие ускоренных методов обнаружения патогенов обусловлено все возрастающими усилиями пищевой промышленности, ее регуляторных органов по контролю качества продуктов питания и поставщиков технологий. Сьюзан Бэркс рассматривает последние разработки в этом направлении
3/2014 (51) июль-сентябрь
- Выбор конструкционного материала и способа санитарной обработки системы распределения воды фармацевтического качества

На стадии проектирования и реализации систем получения воды очищенной (ВО) и воды для инъекций (ВДИ) регулярно встает вопрос о конструкционном материале системы распределения. В последнее время в результате постепенного внедрения надлежащей инженерной практики GEP) и принципов GMP список используемых материалов существенно сократился.
2/2014 (50) апрель-июнь
- Самоинспекция систем водоподготовки. Контрольные вопросы

Заключительная часть статьи. Начало опубликовано в №1 (январь-март) 2014 года.
- Как выбрать «правильный» пар

Статья публикуется с разрешения редакции журнала Cleanroom Technology, апрель 2014 (www.cleanroom-technology.co.uk)
В последнее время появилось осознание того, что промышленный пар оказывается недостаточно чистым для некоторых областей применения. Spirax Sarco рассматривает различные категории пара, используемые в промышленности, и приводит рекомендации по конкретным применениям.
- Фильтрация воды для иммерсионных процессов: удаление наночастиц

По материалам компании Entegris Inc. (www.entegris.com)
1/2014 (49) январь-март
- Самоинспекция систем водоподготовки. Контрольные вопросы

Предлагаем вниманию читателей опросные листы, содержащие 148 контрольных вопросов для проверки соответствия системы водоподготовки на фармацевтическом предприятии требованиям GMP. Приведенные вопросы можно использовать и для обучения внутренних аудиторов, и для проведения самоинспекции системы водоподготовки.
- Критерии соответствия НПП: вода для фармацевтических целей

Рекомендации ВОЗ подготовлены Gordon Farquharson, координатором Международного Сообщества Фармацевтических Инженеров (ISPE), Бельгия. Документ содержит пересмотренный текст, подготовленный Andres Jagomägi, Эстония, и учитывает комментарии, сделанные в период консультаций и дискуссий на совещании, проведенном 23-26 июня 2003
Материал для публикации представлен специалистами компании ООО «УНИКА Инжиниринг»
- Анализ PPQ-уровня сверхчистой деионизованной воды, применяемой на полупроводниковых производствах

Опубликовано по материалам сайта www.mcilvainecompany.com
- Воздушные молекулярные загрязнения (амс) становятся значимым классом загрязнений

Статья публикуется с разрешения редакции журнала Cleanroom Technology, октябрь 2012 (www.deanroom-technology.co.uk)
4/2013 (48) октябрь-декабрь
- Анализ кремния в сверхчистой деионизованной воде для производства полупроводников методом атомноабсорбционной спектрометрии с графитовым атомизатором

Присутствие в сверхчистой деионизованной воде для полупроводникового производства следов кремния может привести к массовому браку изделий, поэтому его остаточный уровень необходимо тщательно контролировать.
3/2013 (47) июль-сентябрь
- Новая концепция потокового анализа бионагрузки воды: ключевые аспекты, способы применения и бизнес-преимущества для минимизации микробиологического риска

Разработка и внедрение потокового анализатора бионагрузки воды (OWBA - online water bioburden analyzer) открывает новые возможности по улучшению функционирования систем водоснабжения в фармацевтической промышленности, снижению расходов и обеспечению качества воды.
2/2013 (46) апрель-июнь
- Важные особенности проектирования и эксплуатации систем водоподготовки на фармацевтическом производстве

Производство лекарственных препаратов – это сложный процесс, начинающийся в исследовательских лабораториях и заканчивающийся выпуском готового лекарственного средства в контролируемых условиях окружающей среды.
4/2012 (44) октябрь-декабрь
- «Гибкие» подходы и решения для фармацевтических производств

Персонал практически любого фармацевтического предприятия каждый день сталкивается с эксплуатацией и обслуживанием технологического оборудования и систем.
2/2012 (42) апрель-июнь
- Стратегии химической фильтрации для контроля молекулярных загрязнений в воздухе. Часть 2

Сейчас производители обладают гораздо более глубокими знаниями в понимании эффекта, оказываемого молекулярными загрязнениями воздуха на окружающую среду чистого помещения.
- Способы оптимизации процесса подготовки деионизованной воды и методов ее контроля при производстве СБИС

В производственно-технологическом комплексе НИИИС для обеспечения кристального производства деионизованной водой используется общепринятая классическая система подготовки деионизованной воды (система ДИВ).
- Руководство по инспектированию систем высокочистой воды

Эти руководящие указания рассматривают оценку и анализ систем высокочистой воды, используемых в производстве лекарственных препаратов и субстанций, главным образом с точки зрения микробиологических аспектов.
1/2012 (41) январь-март
- НЕРА-фильтрация при повышенных температурах

Фильтрация воздуха при повышенных температурах представляет собой сложную задачу с точки зрения эксплуатации и тестирования целостности фильтров.
- Стратегии химической фильтрации для контроля молекулярных загрязнений в воздухе. Часть 1

Контроль воздушных молекулярных загрязнений (ВМЗ) стал неотъемлемой составляющей требований к чистым помещениям на производствах, эксплуатирующих высокие технологии.
3/2011 (39) июль-сентябрь
- Современные методы утилизации промышленных отходов в микроэлектронике

Производство субмикронных интегральных схем -это достаточно длительный и многостадийный процесс, продолжающийся от полутора до 2-х месяцев и состоящий более чем из 500 технологических операций, где применяются десятки самых разных видов химических материалов, реагентов, специальных газов, многие из которых...
4/2010 (36) октябрь-декабрь
- Инспектирование систем обеспечения сжатым воздухом: рекомендации pic/s

Техническое состояние критических инженерных систем, программа их обслуживания и качество технологических сред (вода, сжатый воздух, чистый пар и др.) ...
- Сертификация воздушного компрессора по классификации чистоты сжатого воздуха

В процессе проведения сертификации системы сжатого воздуха в соответствии со стандартом ИСО 8573 «Сжатый воздух» Часть 1: «Загрязнения и классы чистоты» могут возникнуть непредвиденные препятствия.
3/2010 (35) июль-сентябрь
- Инспектирование систем водоподготовки: рекомендации PIC/S

Техническое состояние критических инженерных систем, программа их обслуживания и качество технологических сред (вода, воздух, сжатый воздух, чистый пар и газы) вызывает особый интерес у инспекторов различных регуляторных органов. Данной статьей мы начинаем серию публикаций об ожиданиях компетентных международных организаций в отношении требований к производственной инфраструктуре, связанной с чистыми помещениями.
2/2010 (34) апрель-июнь
- Контроль воздушных фильтров на уровне европейских стандартов

С 26 по 29 апреля 2010 г. в выставочном центре «Крокус-Экспо» походила выставка «Аналитика - 2010», в рамках которой действовал раздел «FiltSep-2010» («Фильтрация и сепарация») и салон «Qeanroom Technology» («Технология чистых помещений»).
1/2010 (33) январь-март
- Шкафы газобаллонные для особочистых газов – Особенности технологического применения

Газобаллонные шкафы предназначены для подачи различных газов и газовых смесей (в том числе токсичных, взрывопожароопасных и агрессивных) в технологическое оборудование с сохранением их исходной чистоты. Данное оборудование входит в состав высокочистых газораспределительных систем, обеспечивающих транспортировку газов с общим...
- Материалы для технологических трубопроводов

Данная статья является рефератом по материалам книги «Проектирование чистых помещений» под редакцией Вильяма Уайта, изданной компанией "Cleanroom", Москва, 2004 г.













